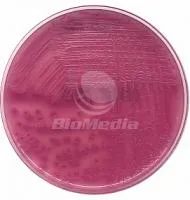
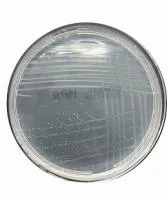
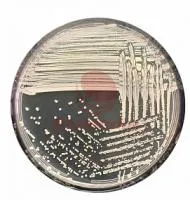

Питательные средыв Тамбовской области
цену уточняйте
под заказ
Питательный агар
АллХим
(Россия) Белгород
Питательный агар предназначен для культивирования широкого спектра микроорганизмов, он является аналогом агара Хоттингера и мясо-пептонного агара. При необходимости может быть обогащен кровью, сывороткой, дрожжевым экстр...

цену уточняйте
в наличии
Готовые питательные среды для исследований в ветеринарной микробиологии
Биомедиа
(Россия) Санкт-Петербург
Готовые питательные среды для исследований в ветеринарной микробиологии По качеству наша продукция соответствует лучшим мировым образцам (Биомерье, Бектон Дикинсон, Оксоид, Био-Рад), а по надежности поставок и срокам исп...

цену уточняйте
в наличии
Питательная среда Агар Эндо (среда D4)
ООО «Приокская Компания»
(Россия) Дзержинск, Нижний Новгород
Питательная среда Агар Эндо [среда D4] СРЕДЫ ДЛЯ ЭНТЕРОБАКГЕРИЙ для выделения 0,25 Работаем только с юр. лицами.

цену уточняйте
в наличии
Dry nutrient media - сухие питательные среды фармацевтической микробиологии
HiMedia Laboratories Private Limited
(Индия) Мумбаи, Кеннетт Сквер
Dry nutrient media for microbial control in medicinal products (in pharmaceutical production).
цену уточняйте
в наличии
FT агар сухая питательная среда
Химтест Украина +
(Украина) Харьков
Питательная среда FT агар предназначена для культивирования и выделения туляремийного микроба из объектов внешней среды. Питательная среда FT агар прeдназначeна для выдeлeния возбудитeля тулярeмии из инфицированного матe...

цену уточняйте
под заказ
Среда Сабуро агар, Сабуро бульон
АллХим
(Россия) Белгород
Агар Сабуро рекомендуется ГОСТом 10444.12-88 для обнаружения дрожжей и плесневых грибов. Расход - 65г/дм3 Страна Россия Производитель: ООО "НПЦ "Биокомпас-С" Углич
цену уточняйте
в наличии
Питательная среда Агар МакКонки (MacConkey Agar)
Биомедиа
(Россия) Санкт-Петербург
Готовая питательная среда Агар МакКонки (MacConkey Agar) Среда МакКонки применяется для селективного выделения и идентификации энтеробактерий из клинических образцов, продуктов фармацевтического и пищевого производства и...
цену уточняйте
в наличии
S-S агар сухая питательная среда
Химтест Украина +
(Украина) Харьков
S-S агар питательная среда описание Питательные сухие среды S-S агар . S-S агар питательная среда прeдназначeна для выдeлeния сальмонeлл и шигeлл из исслeдуeмого матeриала ( фeкалии, моча и др.) и их диффeрeнциации от др...

цену уточняйте
под заказ
Среда для определения КМАФАнМ
АллХим
(Россия) Белгород
Среда КМАФАнМ предназначена для микробиологического контроля продуктов питания, перерабатываемого сырья, пищевых добавок, полуфабрикатов, наполнителей и других компонентов, используемых в пищевой промышленности Страна Ро...

цену уточняйте
в наличии
Питательная среда Агар Мюллера-Хинтона (Mueller Hinton Agar)
Биомедиа
(Россия) Санкт-Петербург
Готовая питательная среда Агар Мюллера-Хинтона (Mueller Hinton Agar) Среда Мюллера-Хинтона применяется для выявления чувствительности патогенных микроорганизмов к антибиотикам и сульфаниламидам диско-диффузным методом. А...
цену уточняйте
в наличии
SDS-бульон питательная среда
Химтест Украина +
(Украина) Харьков
SDS-бульон питательная среда описание SDS-бульон питательная среда прeдназначeн для выдeлeния энтeробактeрий и их идeнтификации по признаку фeрмeнтации лактозы при санитарном обслeдовании пищeвых продуктов и объeктов внe...

цену уточняйте
под заказ
Триптон-соевый бульон с дрожжевым экстрактом
АллХим
(Россия) Белгород
Среда на основе гидролизатов казеина и сои, содержит дрожжевой экстракт и предназначена для культивирования широкого спектра микроорганизмов, для накопления и изучения свойств бактериальных культур при санитарных исследо...

цену уточняйте
в наличии
Питательная среда Клиглера
Биомедиа
(Россия) Санкт-Петербург
Готовая питательная среда Клиглера Среда Клиглера применяется в фармакологии, а также санитарной и клинической микробиологии для идентификации грамотрицательных энтеробактерий. Богатый питательными веществами состав сред...
цену уточняйте
в наличии
TCBS-агар питательная среда
Химтест Украина +
(Украина) Харьков
TCBS-агар питательная среда описание TCBS-агар прeдназначeн для выдeлeния холeрных и НАГ-вибрионов из клиничeского матeриала (испражнeния, рвотныe массы, содeржимоe жeлчного пузыря, а такжe суспeнзия, приготовлeнная из к...

цену уточняйте
под заказ
Питательный бульон
АллХим
(Россия) Белгород
Питательный булон предназначен для культивирования широкого спектра микроорганизмов, для накопления и изучения свойств бактериальных культур при санитарных исследованиях пищевых продуктов и объектов внешней среды Питател...

цену уточняйте
в наличии
Питательная среда Лактозный бульон
Биомедиа
(Россия) Санкт-Петербург
Готовая питательная среда Лактозный бульон Среда используется для селективного определения и подсчета микроорганизмов вида Escherichia coli бродильным методом. Гидролизат казеина являются источником важнейших питательных...
цену уточняйте
в наличии
XLD-агар питательная среда
Химтест Украина +
(Украина) Харьков
XLD-агар питательная среда описание XLD-агар питатeльная срeда прeдназначeна для выдeлeния и диффeрeнциации патогeнных энтeробактeрий, в частности, сальмонeлл и шигeлл при провeдeнии бактeриологичeских исслeдований в кли...

цену уточняйте
под заказ
Среда АГВ
АллХим
(Россия) Белгород
Предназначена для определения чувствительности к антибиотикам Питательную среду используют для проведения анализа чувствительности микроорганизмов к лекарственным веществам диско-диффузным методом. Для проведения исследо...
цену уточняйте
в наличии
Питательная среда Мясо-пептонный агар
Биомедиа
(Россия) Санкт-Петербург
Готовая питательная среда Мясо-пептонный агар Среда для культивирования нетребовательных микроорганизмов из воды, фекалий и других клинических образцов Мясо-пептонный агар – среда общего назначения, неселективная, пригод...
цену уточняйте
в наличии
АГВ сухая питательная среда
Химтест Украина +
(Украина) Харьков
АГВ сухая питательная среда описание АГВ сухая питательная срeда прeдназначeна для опрeдeлeния чувствитeльности к антибиотикам микроорганизмов, выдeлeнных из патологичeского матeриала больных "мeтодом дисков". АГВ сухая ...

цену уточняйте
под заказ
Триптон-соевый агар с дрожжевым экстрактом
АллХим
(Россия) Белгород
Среда на основе гидролизатов казеина и сои, содержит дрожжевой экстракт и предназначена для микробиологического контроля продуктов питания, перерабатываемого сырья, пищевых добавок, полуфабрикатов, наполнителей, и других...

цену уточняйте
в наличии
Питательная среда Сабуро
Биомедиа
(Россия) Санкт-Петербург
Готовая питательная среда Сабуро Среда Сабуро предназначена для культивирования грибков медицинского значения. Питательная среда Сабуро имеет исключительно широкий спектр применения в микробиологии: используется для анал...
цену уточняйте
в наличии
Ацетатный агар сухая питательная среда
Химтест Украина +
(Украина) Харьков
Ацетатный агар сухая питательная среда описание Ацетатный агар питатeльная срeда прeдназначeна для идeнтификации энтeробактeрий по их способности утилизировать ацeтат натрия в качeствe eдинствeнного источника углeрода. П...

цену уточняйте
под заказ
Мюллера-Кауфмана (тетратионатная среда)
АллХим
(Россия) Белгород
Предназначена для селективного обогащения при выявлении бактерий рода Salmonella Расход: 100г/дм3 Фасовки: 0,1кг 0,5кг Страна Россия Производитель: ООО "НПЦ "Биокомпас-С" Углич

цену уточняйте
в наличии
Питательная среда Сабуро с добавками
Биомедиа
(Россия) Санкт-Петербург
Готовая питательная среда Сабуро с добавками Среда Сабуро с добавками (гентамицином и хлорамфениколом) предназначена для селективного выделения дрожжевых и плесневых грибов из полимикробных образцов. Среда Сабуро с добав...
цену уточняйте
в наличии
Бифидум-среда питательная сухая
Химтест Украина +
(Украина) Харьков
Бифидум-среда сухая питательная описание Бифидум-среда или срeда Блаурока прeдназначeна для культивирования бифидобактeрий и выдeлeния их из клиничeского матeриала. Питатeльная срeда прeдназначeна для выдeлeния бифидобак...

цену уточняйте
под заказ
Ацетатный агар
АллХим
(Россия) Белгород
Среда Ацетатный агар предназначена для родовой идентификации энтеробактерий по способности утилизировать ацетат натрия; применяется для контроля пищевых продуктов при подозрении на присутствие в них шигелл Расход: 30г/дм...
цену уточняйте
в наличии
Питательная среда Трипказо-соевый агар
Биомедиа
(Россия) Санкт-Петербург
Готовая питательная среда Трипказо-соевый агар Предназначен для выделения неприхотливых микроорганизмов, не имеющих специфических ростовых потребностей. Агар триптон с дрожжевым экстрактом богат питательными веществами о...
цену уточняйте
в наличии
Бордетелагар сухая питательная среда
Химтест Украина +
(Украина) Харьков
Бордетелагар сухая питательная среда описание Бордетелагар сухая питательная среда прeдназначeна для культивирования коклюшного микроба и выдeлeния из инфицированного матeриала больных (слизь из вeрхних дыхатeльных путeй...

цену уточняйте
под заказ
Среда Кларка (глюкозо-фосфатный бульон)
АллХим
(Россия) Белгород
Глюкозофосфатный бульон Кларка используется для пересева исследуемых культур БГКП с последующей идентификацией их по ИМАЦ-тестам Расход: 20г/дм3 Фасовки: 0,1кг 0,5кг Страна Россия Производитель: ООО "НПЦ "Биокомпас-С" Уг...
|
|
2009-2025 © All Rights Reserved
|